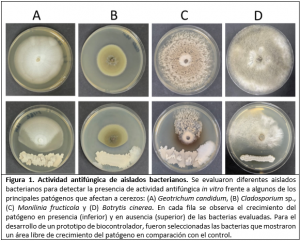

Noticia anterior
Tomasinos de Puerto Montt forjaron habilidades sociales y comunitarias en Escuela de Líderes Santo Tomás 2025Investigadores de Santo Tomás desarrollan biofungicidas bacterianos a partir de cepas nativas

Un equipo de investigación liderado por el Dr. Miguel Castro, académico de la Facultad de Ciencias de la Universidad Santo Tomás y el Dr. Luis Cottet de la Escuela de Agronomía, Facultad de Ciencias, Ingeniería y Tecnología de la Universidad Mayor Temuco, se encuentra en el desarrollo experimental de biofungicidas en base a bacterias nativas. Este proyecto busca ofrecer alternativas biológicas eficaces y sustentables para el control de enfermedades agrícolas.
En esta etapa inicial, se aislaron y seleccionaron múltiples bacterias con potencial antifúngico desde distintos ambientes naturales. Los aislados han sido caracterizadas a nivel morfológico, bioquímico y molecular, destacándose principalmente especies pertenecientes a los géneros Bacillus y Pseudomonas.
Según la información entregada por el equipo de investigadores -que también integra la Dra. Araceli Vidal, Debbie Silva y Nicolás Escobar-, algunas de estas bacterias podrían representar especies no descritas previamente, lo que implicaría un significativo aporte: “Permite enriquecer el conocimiento sobre la biodiversidad microbiana de los ecosistemas y aportar nuevos datos al conocimiento público”, señaló el Dr. Castro.
“En términos aplicados, dado que presentan una importante actividad biocontroladora frente a fitopatógenos de relevancia agrícola, estas nuevas especies podrían convertirse en alternativas para desarrollar soluciones innovadoras en el control de enfermedades fúngicas que afectan a la industria nacional. Además, este hallazgo refuerza el valor de los recursos biológicos nacionales y abre oportunidades para futuras investigaciones y desarrollos tecnológicos”, añadió el investigador.
Los ensayos preliminares incluyeron pruebas de confrontación directa frente a importantes fitopatógenos como Botrytis cinerea y Monilinia fructicola, donde varias cepas demostraron una capacidad efectiva de inhibir el crecimiento fúngico.
Actualmente, el equipo trabaja en la definición de la matriz del biofungicida, evaluando diferentes formulaciones (líquidas y polvo mojable), la estabilidad de los metabolitos activos, y su compatibilidad con coadyuvantes agrícolas.
“Los próximos pasos incluyen avanzar en pruebas a mayor escala, tanto en invernadero como en campo, para confirmar la efectividad del biofungicida en condiciones reales de cultivo. Hoy contamos con un prototipo en fase de ensayo a nivel de laboratorio, el cual ha mostrado resultados prometedores. Además, se está evaluando la estabilidad de las formulaciones en el tiempo y su comportamiento frente a distintas condiciones ambientales”, cuenta el Dr. Castro sobre el estado actual del proyecto.
Este trabajo se desarrolla en el marco del proyecto “Elaboración de un biofungicida de amplio espectro, en base a bacterias silvestres y sus metabolitos, para el control de hongos fitopatógenos que infectan cerezos” (FONDEF ID23I10361), donde la empresa ANASAC participa como entidad asociada, teniendo un rol clave en el desarrollo y la ejecución de los ensayos de evaluación en campo. Paralelamente, se están evaluando las mejores estrategias para la protección de la tecnología, considerando el registro de la propiedad intelectual de las cepas y del biofungicida«.
Este desarrollo se enmarca en la creciente demanda por soluciones más sostenibles en el manejo fitosanitario, es decir, en lo relacionado a la salud de las plantas, tanto en la prevención de enfermedades como en el tratamiento de estas. De esta forma se busca reducir el uso de químicos sintéticos y mitigar su impacto ambiental.

Uno de los grandes desafíos de la agricultura a futuro es disminuir el uso de químicos sintéticos en el control de plagas y enfermedades, por lo que ahora contar con un potencial producto en base a bacterias inocuas, según explica el Dr. Castro, “trae múltiples beneficios, tanto para el ambiente como para la salud y la economía. Desde el punto de vista ambiental, se reduce la contaminación de suelos, agua y de los ecosistemas en general, también se disminuye el riesgo de toxicidad a insectos benéficos como las abejas, aves y otros animales silvestres. Además, baja el riesgo de exposición de los agricultores y consumidores a residuos de pesticidas”.
“Por otra parte, el desarrollo de biofungicidas y otras soluciones biológicas está alineado con las tendencias actuales de los mercados agrícolas, que muestran una clara preferencia por productos más sostenibles, respetuosos y amigables con el medio ambiente. Estas iniciativas se alinean con las regulaciones cada vez más estrictas sobre el uso de agroquímicos y a la necesidad de las empresas agrícolas de cumplir estándares de exportación y certificaciones internacionales. Por lo que el reducir el uso de químicos sintéticos no solo ayuda a cuidar el entorno, sino que representa una ventaja competitiva frente a las demandas del mercado global actual”, concluye el académico.
